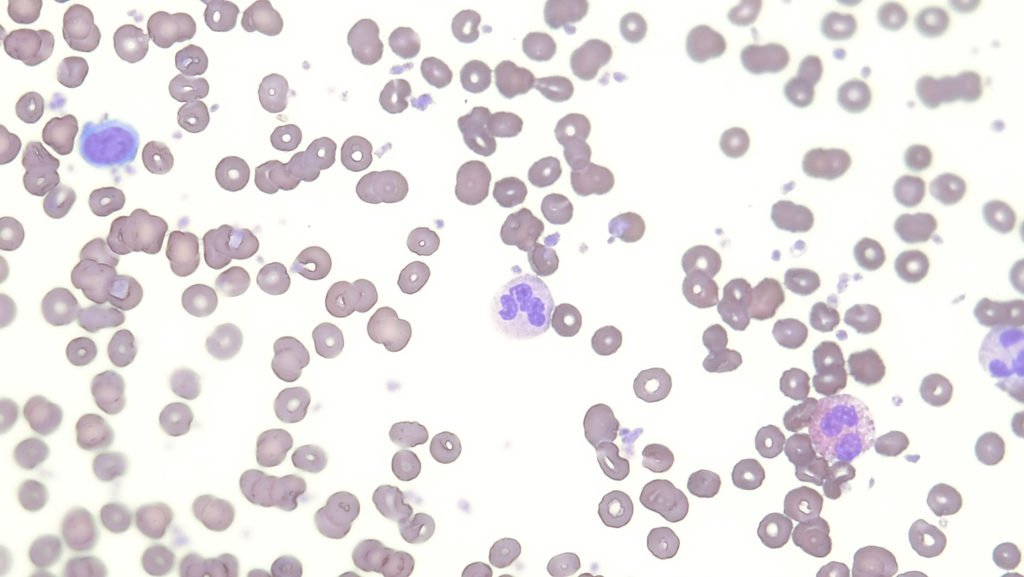
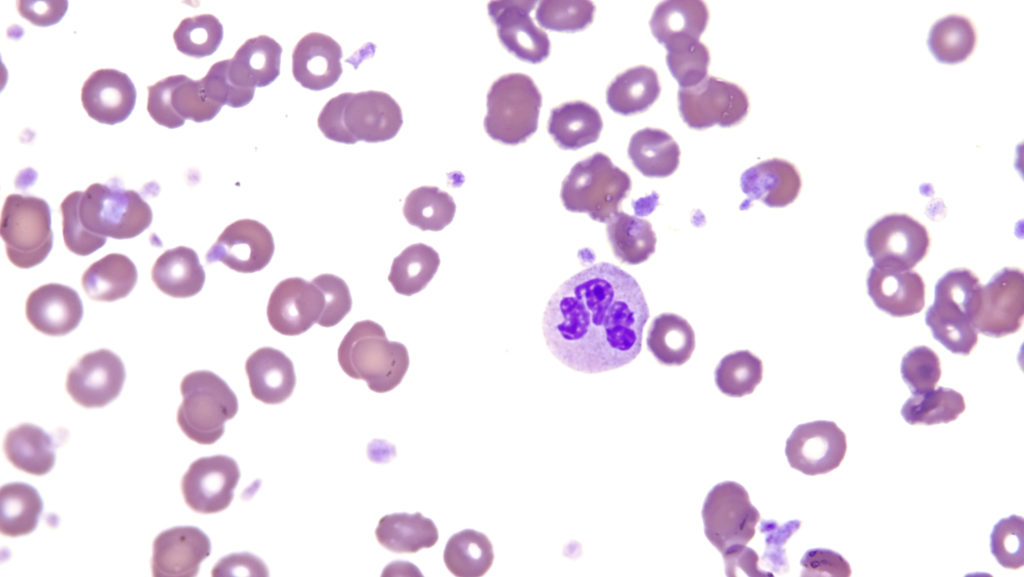
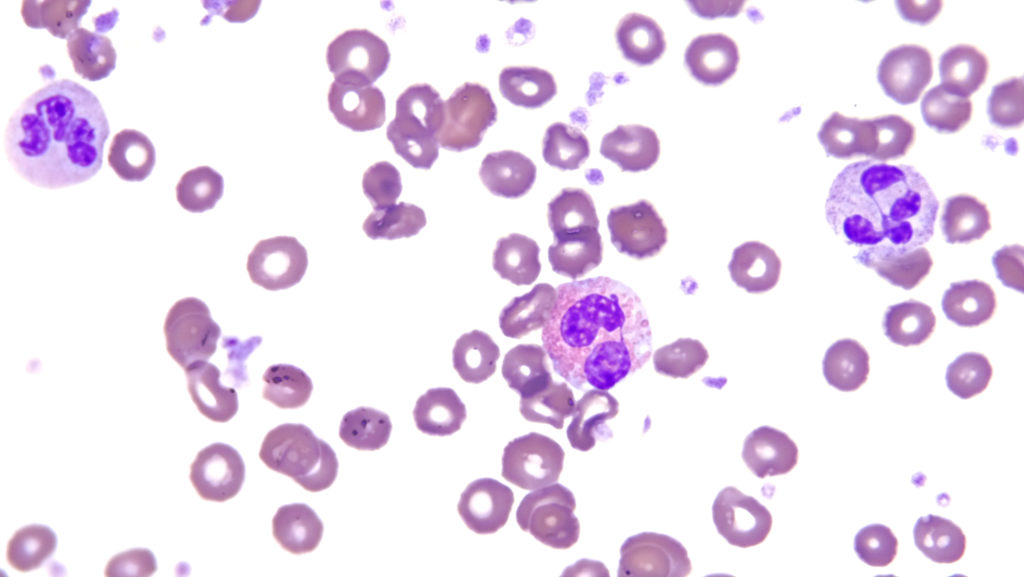
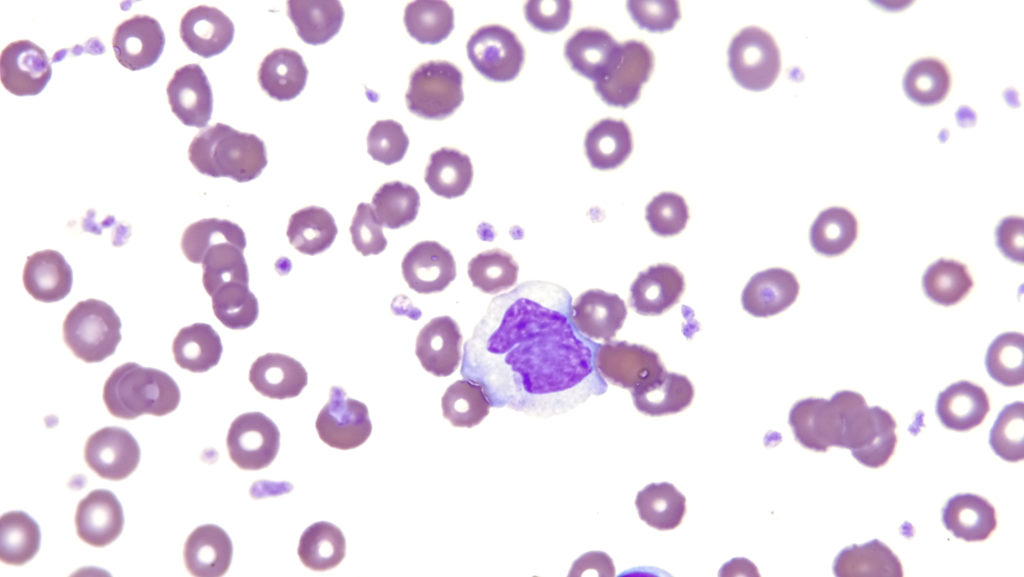

顕微鏡写真: Diff-Quik染色
そう言えば、今まで染色について触れてくることのないままにひたすら顕微鏡写真を紹介していましたので、今回は当サイトによく出てくるDiff-Quik染色についてお話していきたいと思います。

むかしむかし、19世紀の終わりの頃に血液塗抹をどうにかして詳しく観察したいという研究者の方々が、アズール色素やエオジンという色素を使うと良いぞということに至りました。中でも、ロマノフスキーさんという方が発見した方法は、アズール色素(青)とエオジン(赤)で染めているにもかかわらず、核が紫色に染まったりして元の色素以外の様々な色調があらわれることで有名になりました。それをロマノフスキー効果と呼び、その原理に基づいた染色方法のことをロマノフスキー染色と総称します。
メイ・グリュンワルド染色、ライト染色、ギムザ染色など有名な染色法はすべてロマノフスキー染色の一種であり、主に医学の方ではメイ・グリュンワルド・ギムザ染色、獣医学の方ではライト・ギムザ染色が用いられているように思います。当院では主にライト・ギムザ染色です。過去にメイ・グリュンワルド・ギムザ染色とライト・ギムザ染色を頑張って比較してみたことがあるのですが、若干、メイ・グリュンワルド・ギムザ染色は核の細かい構造が優しい染まりあがりだったかなという誤差範囲くらいの印象で、正直私のようなアマチュアの目には大きな違いが分かりませんでした笑
血液塗抹の細かい部分を丁寧に観察する場合、やはりライト・ギムザ染色やメイ・グリュンワルド・ギムザ染色の方が繊細で分かりやすいですが、なにぶん少しだけ時間を要します。だいたい20-30分くらいでしょうか。たかが20-30分くらいの時間なので、コーヒーでも飲みながら落ち着いて染色して結果を待てば良いのですが、動物病院の診療はやたらとスピードが要求されるので、全例でライト・ギムザ染色を実施するのは少し困難です。そこで普及したのが、簡易迅速染色であるDiff-Quik染色です。
Diff-Quik染色もロマノフスキー染色の変法のひとつなのですが、メーカーさん曰く固定から染色までがわずか15秒で行えると。私は15秒で染めるときの仕上がりがあまり好きではないので、固定から染色まで2分くらいかけるように自己流で調整して行っていますが、それでも上述のライト・ギムザ染色などに比べれば圧倒的に早いです。たとえば、自動血球計数器で血小板数低値が出た場合、血小板凝集の有無を確認するだけなら20-30分もかけてライト・ギムザ染色を行うより、絶対にDiff-Quik染色の方が便利です。
ただDiff-Quik染色の難点として、白血球など核の細かい構造に対する染色性がライト・ギムザ染色よりも劣ります。したがって、白血病の診断など幼若細胞の判定を行いたい場合はDiff-Quik染色は不向きなように思っているので、その場合は診療が落ち着いたところでゆっくりライト・ギムザ染色を実施するようにしています。染色だけではなく細胞形態の観察もじっくり行いたいですからね。なお、同じ血液塗抹なのですが撮影条件が異なるのでだいぶ弱拡大と強拡大で染色性の見え方が異なっていてすいません。

以上です。ちなみに今日のDiff-Quik染色の写真はすべてヒトの血液の写真です。なぜかというと、怪我したときに顕微鏡がそばにあったらスライドガラスに塗布して見てみたくなりますよね?皆さんもそうですよね?え、違いますか?


